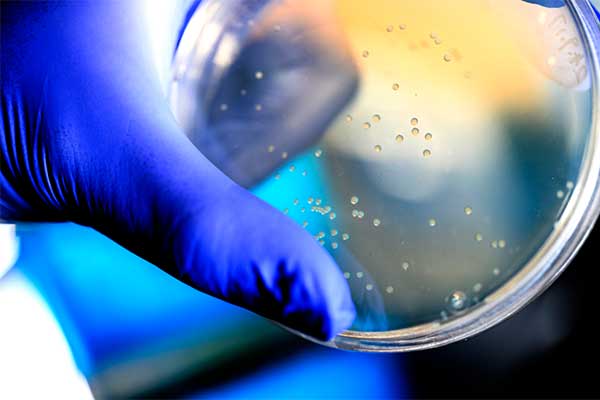

Chiara Bellini
Associate Professor and Associate Chair for PhD Program and Research,
Bioengineering
Contact
- c.bellini@northeastern.edu
- 360 Huntington Avenue
Boston, MA 02115
Office
- 228 ISEC
- 617.373.2550
Research Focus
Diseases of the cardiovascular system; effects of cellmediated growth and remodeling processes on tissue and organ mechanics
Education
- 2012 PhD in Biomedical Engineering, The University of Calgary
- 2008 MSc in Biomedical Engineering, Politecnico di Milano, Italy
- 2005 BSc in Biomedical Engineering, Politecnico di Milano, Italy
Research Overview
Diseases of the cardiovascular system; effects of cellmediated growth and remodeling processes on tissue and organ mechanics
Selected Research Projects
- Cardiopulmonary Outcomes of Dual Cigarette and E-cigarette Use in Animal Models of Chronic Exposure
- – Principal Investigator, National Institute of Health
- Cardiopulmonary Risk Assessment from Smoke Exposure at the Wildland Urban Interface
- – co-Principal Investigator, National Institutes of Health
- Continuous, Non-Invasive Optical Monitoring of Circulating Tumor Cell-Mediated Metastasis in Awake Mice
- – Principal Investigator, National Cancer Insititute and NIH
- Evaluation of Aortic Stiffening as an Early Indicator of Anthracycline-Induced Cardiotoxicity
- – Principal Investigator, National Institute of Health
- Health Consequences Following Acute and Chronic Firefighter Exposure to Wildland Fire Smoke
- – Principal Investigator, Department of Homeland Security, Federal Emergency Management Agency
- Pulmonary and Cardiovascular Health Consequences Following Electronic Cigarette Exposure
- – Principal Investigator, National Institute of Health
Research Centers and Institutes
Department Research Areas
Selected Publications
- Augustin, Christoph M., Fastl, Thomas E., Neic, Aurel, Bellini, Chiara, Whitaker, John, Rajani, Ronak, O’Neill, Mark D., Bishop, Martin J., Plank, Gernot, Niederer, Steven A. (2020). The impact of wall thickness and curvature on wall stress in patient-specific electromechanical models of the left atrium. Biomechanics and Modeling in Mechanobiology, 19(3),1015-1034. 10.1007/S10237-019-01268-5
- Boytard, Ludovic, Hadi, Tarik, Silvestro, Michele, Qu, Hengdong, Kumpfbeck, Andrew, Sleiman, Rayan, Fils, Kissinger Hyppolite, Alebrahim, Dornazsadat, Boccalatte, Francesco, Kugler, Matthias, Corsica, Annanina, Gelb, Bruce E., Jacobowitz, Glenn, Miller, George, Bellini, Chiara, Oakes, Jessica, Silvestre, Jean-Sébastien, Zangi, Lior, Ramkhelawon, Bhama (2020). Lung-derived HMGB1 is detrimental for vascular remodeling of metabolically imbalanced arterial macrophages. Nature Communications, 11(1). 10.1038/S41467-020-18088-2
- Dong, Melody, Oakes, Jessica M., Bellini, Chiara, Rayz, Vitaliy L., LaDisa, John F., Parker, Dave, Wilson, Nathan M., Shadden, Shawn C., Marsden, Alison L., Goergen, Craig J., Boster, Kimberly A. Stevens (2020). Integrated Image-Based Computational Fluid Dynamics Modeling Software as an Instructional Tool. Journal of Biomechanical Engineering, 142(11). 10.1115/1.4047479
- Farra, Yasmeen M., Eden, Matthew J., Coleman, James R., Kulkarni, Praveen, Ferris, Craig F., Oakes, Jessica M., Bellini, Chiara (2020). Acute neuroradiological, behavioral, and physiological effects of nose-only exposure to vaporized cannabis in C57BL/6 mice. Inhalation Toxicology, 32(5),200-217. 10.1080/08958378.2020.1767237
- Fitzgerald, Jessica E., Byrd, Brook K., Patil, Roshani A., Strawbridge, Rendall R., Davis, Scott C., Bellini, Chiara, Niedre, Mark (2020). Heterogeneity of circulating tumor cell dissemination and lung metastases in a subcutaneous Lewis lung carcinoma model. Biomedical Optics Express, 11(7),3633. 10.1364/BOE.395289
- Mueller, Amy V., Eden, Matthew J., Oakes, Jessica M., Bellini, Chiara, Fernandez, Loretta A. (2020). Quantitative Method for Comparative Assessment of Particle Removal Efficiency of Fabric Masks as Alternatives to Standard Surgical Masks for PPE. Matter, 3(3),950-962. 10.1016/J.MATT.2020.07.006
- Spronck, Bart, Ferruzzi, Jacopo, Bellini, Chiara, Caulk, Alexander W., Murtada, Sae-Il, Humphrey, Jay D. (2020). Aortic remodeling is modest and sex-independent in mice when hypertension is superimposed on aging. Journal of Hypertension, 38(7),1312-1321. 10.1097/HJH.0000000000002400
- A. Korneva, L. Zilberberg, D.B. Rifkin, J.D. Humphrey, C. Bellini, Absence of LTBP-3 Attenuates the Aneurysmal Phenotype But Not Spinal Effects on the Aorta in Marfan Syndrome, Biomechanics and Modeling in Mechanobiology, 18(1), 2019,261-273
- C. Bellini, N.J. Kristofik, M.R. Bersi, T.R. Kyriakides, J.D. Humphrey, A Hidden Structural Vulnerability in the Thrombospondin-2 Deficient Aorta Increases the Propensity to Intramural Delamination, Journal of the Mechanical Behavior of Biomedial Materials, 71, 2017, 397-406
- C. Bellini, M.R. Bersi, A. Caulk, J. Ferruzzi, D.M. Milewicz, F. Ramirez, D.B. Rifkin, G. Tellides, H. Yanagiswa, J.D. Humphrey, Comparison of Ten Murine Models Reveals a Distinct Biomechanical Phenotype in Thoracuc Aortic Aneurysms, Journal of the Royal Society Interface, 14(130), 2017

Apr 01, 2026
Northeastern Engineering Professors on the Lack of Representation in Medical Research
MIE/BioE Professor Sandra Shefelbine and BioE Associate Professor Chiara Bellini discuss the lack of representation of women in medicine and medical research, specifically in their research areas of bone biomechanics and cardiovascular health–respectively.

Jan 22, 2026
Driven by Impact: A Bioengineering Researcher’s Story
Mahsa Karamzadeh, PhD ’27, bioengineering, blends her passion for engineering and call to service to fuel her research. Recently, Karamzadeh and her team published their study on Chiari Type 1 patients in the Magnetic Resonance Imaging journal.

Oct 15, 2025
Using 3D Modeling to Track Wildfire Smoke Deposition in the Lungs
Research from BioE Associate Professors Jessica Oakes and Chiara Bellini’s lab on “Computational assessment of the impact that wildland fire smoke exposure has on airflow and particle deposition in the mouse respiratory tract” was published in Computers in Biology and Medicine.

Jun 09, 2025
Skalak Award Honorable Mention for Paper on Vascular Remodeling During Pregnancy
Ana I. Vargas, PhD’25, bioengineering, BioE Associate Professor Chiara Bellini and MIE Associate Professor Rouzbeh Amini received an Honorable Mention for the 2025 Skalak Award for their paper on “Vascular Remodeling During Late-Gestation Pregnancy: An In-Vitro Assessment of the Murine Ascending Thoracic Aorta.”

Jan 24, 2025
Researchers Warn of Damaging Effects of Smoke From California Fires
Bioengineering Associate Professors Chiara Bellini and Jessica Oakes highlight the dangerous health effects of inhaling wildfire smoke. Their research provides insight into the risks the California wildfires pose for people’s respiratory and cardiovascular systems.

Oct 17, 2024
Engineering for Women’s Health Conference 2024 Focuses on Interdisciplinary Solutions
Seeking to highlight the need for interdisciplinary and collaborative approaches to women’s health, a group of bioengineering and mechanical engineering PhD students organized the inaugural Engineering for Women’s Health Conference 2024.
Oct 08, 2024
New Approaches to Treatment-Resistant Tumors
Shaobo Yang, PhD’24, bioengineering, advised by BioE Associate Professor Chiara Bellini, published research on “Non-Pathogenic E. Coli Displaying Decoy-Resistant IL18 Mutein Boosts Anti-Tumor and CAR NK Cell Responses” in Nature Biotechnology.
May 08, 2024
2024 URF Scholars Recipients
Several engineering students received 2024 URF Scholars Awards from Northeastern’s Office of Undergraduate Research and Fellowships. URF Scholars are students who are graduating this year and who have earned a PEAK Experiences Award, applied for a distinguished fellowship, or participated in graduate school advising.
May 07, 2024
Summer 2024 PEAK Experiences Awardees for Undergrad Research
Several engineering and science students mentored by COE faculty are recipients of the Summer 2024 PEAK Experiences Awards from Northeastern’s Office of Undergraduate Research and Fellowships.

Apr 25, 2024
Celebrating Affinity Student Groups at the 18th Annual Joint Recognition Banquet
Students, faculty, staff, alumni, and corporate partners were recognized for their commitments to several COE affinity student groups at the 18th Annual Joint Recognition Banquet. The groups represented included SHPE, SWE, BESS, SASE, and DICE.
